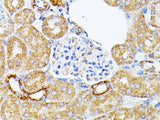
ECE1 Polyclonal Antibody

ECE1 Polyclonal Antibody
SKU: E-AB-93351-200
ECE1 Polyclonal Antibody
| SKU # | E-AB-93351 |
| Reactivity | Human, Mouse, Rat |
| Host | Rabbit |
| Applications | IHC, IF |
Product Details
| Isotype | IgG |
| Host | Rabbit |
| Reactivity | Human, Mouse, Rat |
| Applications | IHC, IF |
| Clonality | Polyclonal |
| Immunogen | Recombinant fusion protein of human ECE1 |
| Abbre | ECE1 |
| Synonyms | ECE, endothelin-converting enzyme 1, ECE1 |
| Swissprot | |
| Calculated MW | 85 kDa/87 kDa |
| Observed MW | Refer to figures |
| Cellular Localization | Cell membrane, Single-pass type II membrane protein. |
| Concentration | 1 mg/mL |
| Buffer | Phosphate buffered solution, pH 7.4, containing 0.05% stabilizer and 50% glycerol. |
| Purification Method | Affinity purification |
| Research Areas | Cancer, Cardiovascular, Metabolism, Signal Transduction |
| Conjugation | Unconjugated |
| Storage | Store at -20°C Valid for 12 months. Avoid freeze / thaw cycles. |
| Shipping | The product is shipped with ice pack,upon receipt,store it immediately at the temperature recommended. |
Related Reagents
| Applications | Recommended Dilution |
| IHC | 1:50-1:200 |
| IF | 1:50-1:200 |
Background
The protein encoded by this gene is involved in proteolytic processing of endothelin precursors to biologically active peptides. Mutations in this gene are associated with Hirschsprung disease, cardiac defects and autonomic dysfunction. Alternatively spliced transcript variants encoding different isoforms have been noted for this gene.